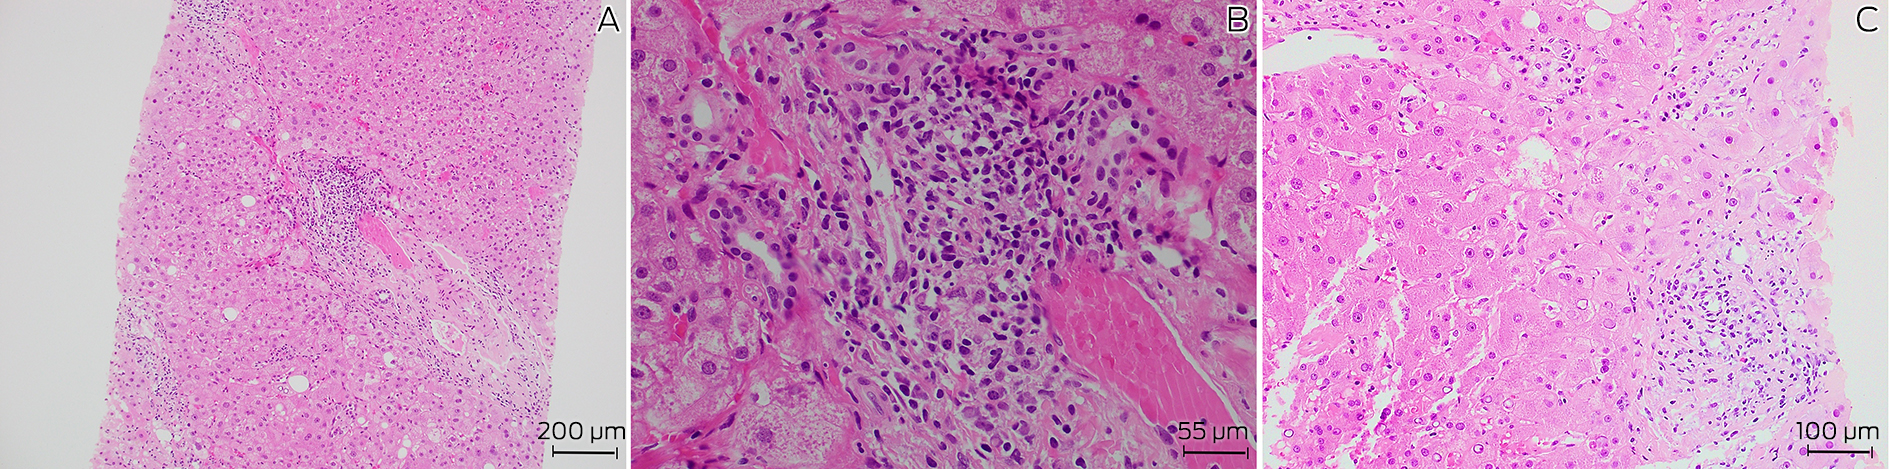

Clinical record
A 72‐year‐old man with a history of well controlled type 2 diabetes was admitted to a tertiary metropolitan hospital for investigation of fevers, night sweats and unintentional weight loss of 18 kg over six months. He had pancytopenia with no symptoms or signs to suggest a focal infection, malignancy or rheumatological disease. Prior outpatient investigation findings revealed mild splenomegaly, with a normal bone marrow aspirate and positron emission tomography scan. At its nadir, the haemoglobin level was 106 g/L (reference interval [RI], 125–175 g/L), white cell count 1.9 × 109/L (RI, 4.0–11.0 × 109/L), neutrophil count 1.2 × 109/L (RI, 2.00–8.00 × 109/L) and platelets 120 × 109/L (RI, 150–450 × 109/L). Notably, liver function test results were mildly elevated in a mixed pattern with alkaline phosphatase 138 U/L (RI, 30–110 U/L), γ‐glutamyl transferase 605 U/L (RI, 5–50 U/L) and alanine aminotransferase 78 U/L (RI, 5–40 U/L), with associated antinuclear antibody titre of more than 1280 (RI, < 160), and an elevated immunoglobulin G level of 38.6 g/L (RI, 7.5–15.6 g/L). Pertinent negative results included negative human immunodeficiency virus (HIV) and viral hepatitis serology, and negative anti‐smooth muscle and anti‐liver–kidney microsomal antibodies. Given these findings and the ongoing diagnostic dilemma, a liver biopsy was performed, showing mild interface hepatitis and lymphoplasmacytic infiltrate in the portal tracts (Box 1), and leading to a probable diagnosis of autoimmune hepatitis. Administration of azathioprine 25 mg and prednisolone 40 mg daily was initiated and the patient was discharged following improvement of his liver function test results.
The patient re‐presented two weeks later due to worsening night sweats with no new localising symptoms and was found to have febrile neutropenia (neutrophil count, 0.4 × 109/L). Administration of empiric antibiotics was started, and azathioprine was stopped due to possible contribution to worsening myelosuppression. As the patient was born in coastal Greece and had travelled there two years prior, leishmaniasis was raised as a differential diagnosis. A repeat bone marrow aspirate revealed Leishmania amastigotes under microscopy (Box 2) and polymerase chain reaction (PCR) testing was positive for Leishmania donovani complex. The patient was treated with intravenous liposomal amphotericin 3 mg/kg/dose on Days 1–5, Day 14 and Day 21, which led to resolution of symptoms and pancytopenia six weeks after treatment.
Discussion
Visceral leishmaniasis is a vector‐borne zoonotic disease primarily caused by parasites of the L. donovani complex (includes L. donovani and Leishmania infantum) and is transmitted via infected sandflies.1 Globally, visceral leishmaniasis features on the World Health Organization list of neglected tropical diseases, with a significant burden in tropical and subtropical regions, including Northern Africa, South America, Western Asia, southern Europe and the Mediterranean.1,2 In Australia, the only native Leishmania species is Leishmania australiensis, which occurs in macropods (eg, kangaroos, wallabies, wallaroos) and is not known to cause human disease. Consequently, all reported cases have occurred in travellers from endemic regions.3
Visceral leishmaniasis usually presents with an insidious onset of constitutional symptoms, pancytopenia, hepatomegaly and splenomegaly (which may be massive), due to replication of parasites in the reticuloendothelial system.4 Complications range from bleeding, hepatic dysfunction and neutropenic infections to disseminated intravascular coagulation and haemophagocytic lymphohistiocytosis. Untreated disease is associated with a high mortality rate.5 The incubation period is usually months, although may range from a few weeks to several years. In this case, the patient had not travelled to Greece or other endemic areas in two years, reflecting a prolonged incubation period. This highlights the importance of obtaining an extended travel history for diagnoses, as well as in screening for latent infections before commencing immunosuppressive medications.
Traditionally, definitive diagnosis of visceral leishmaniasis requires visualisation of parasites on a tissue smear of bone marrow or splenic aspirates. However, sensitivity depends on thorough microbiological examination,6 and biopsies may be associated with procedural risks such as splenic haemorrhage, particularly given the increased bleeding tendency in visceral leishmaniasis. Alternatively, molecular testing with PCR of peripheral blood, bone marrow and splenic tissue is sensitive, exceeding microbiological examination in some studies,7 although this approach is limited to specialised laboratories. Serological diagnosis using the rK39 antigen also carries reasonable sensitivity. In endemic regions, PCR and serological testing may be less specific as subclinical carriers and treated cases may express positive results.8 Additionally, serology has limited value in immunocompromised patients who do not mount a serological response to leishmaniasis, although this is not a concern for PCR testing. Overall, in non‐endemic regions, PCR testing with supportive clinical and epidemiological features is an appropriate modality for diagnosis.
In this patient, the diagnosis of visceral leishmaniasis was confounded by an initial diagnosis of autoimmune hepatitis. The association between visceral leishmaniasis with autoantibodies, hypergammaglobulinemia and histopathological features mimicking autoimmune hepatitis has been previously described in the literature.9,10 Proposed mechanisms include tissue destruction by parasites leading to release of tissue antigens and inducing autoreactivity with autoantibody production; and stimulation of polyclonal B cell activation in visceral leishmaniasis leading to hypergammaglobulinemia.11 Due to these immunological phenomena, visceral leishmaniasis has also been shown to mimic other autoimmune diseases, including systemic lupus erythematosus.10 Mistreatment with immunosuppressive therapy may be detrimental, potentially leading to worsening of visceral leishmaniasis symptoms and precipitating secondary bacterial infections.
Treatment of visceral leishmaniasis varies regionally due to drug susceptibility, availability and cost, with liposomal amphotericin B being the preferred agent in resource‐rich countries based on its superior antimicrobial efficacy and safety profile. Further treatment considerations are also required for immunocompromised individuals, especially in HIV–L. donovani complex co‐infection whereby cellular immunity is depleted, and antimicrobial therapy may be inadequate without immune reconstitution. There are no guidelines for the management of visceral leishmaniasis in Australia and our treatment regimen reflects that of North American guidelines.12
In summary, visceral leishmaniasis is seldom found in Australia and remains a rare differential diagnosis for pancytopenia and pyrexia of unknown origin. However, with increasing globalisation, this diagnosis should be entertained in people arriving or returning from endemic countries.
Lessons from practice
- Consider visceral leishmaniasis as a differential diagnosis for pancytopenia and pyrexia of unknown origin in individuals with a travel history to tropical and subtropical regions outside of Australia.
- Visceral leishmaniasis has a variable and occasionally prolonged incubation period and an extended travel history may be required.
- Identification of parasites on bone marrow or splenic tissue is required for definitive diagnosis but a positive polymerase chain reaction test with supportive clinical and epidemiological features is appropriate in non‐endemic areas.
- Visceral leishmaniasis may mimic autoimmune diseases such as autoimmune hepatitis and systemic lupus erythematosus by inducing autoantibodies and hypergammaglobulinemia.
Box 1 – Histopathology of liver biopsy showing (A) chronic inflammation and fibrosis of a portal tract (hematoxylin and eosin staining, 100 × magnification), (B) prominent plasma cells in portal tracts (hematoxylin and eosin staining, 400 × magnification), and (C) epitheliod granuloma (hematoxylin and eosin staining, 200 × magnification)
Provenance: Not commissioned; externally peer reviewed.
- 1. Mann S, Frasca K, Scherrer S, et al. A review of leishmaniasis: current knowledge and future directions. Curr Trop Med Rep 2021; 8: 121‐132.
- 2. Ruiz‐Postigo JA, Jain S, Mikhailov A, et al. Global leishmaniasis surveillance: 2019–2020, a baseline for the 2030 roadmap. Wkly Epidemiol Rec 2021; 35: 401‐419.
- 3. Roberts T, Barratt J, Sandaradura I, et al. Molecular epidemiology of imported cases of leishmaniasis in Australia from 2008 to 2014. PLoS One 2015; 10: e0119212.
- 4. Burza S, Croft SL, Boelaert M. Leishmaniasis. Lancet 2018; 392: 951‐970.
- 5. Seaman J, Mercer AJ, Sondorp E. The epidemic of visceral leishmaniasis in western Upper Nile, southern Sudan: course and impact from 1984 to 1994. Int J Epidemiol 1996; 25: 862‐871.
- 6. da Silva MR, Stewart JM, Costa CH. Sensitivity of bone marrow aspirates in the diagnosis of visceral leishmaniasis. Am J Trop Med Hyg 2005; 72: 811‐814.
- 7. Antinori S, Calattini S, Longhi E, et al. Clinical use of polymerase chain reaction performed on peripheral blood and bone marrow samples for the diagnosis and monitoring of visceral leishmaniasis in HIV‐infected and HIV‐uninfected patients: a single‐center, 8‐year experience in Italy and review of the literature. Clin Infect Dis 2007; 44: 1602‐1610.
- 8. le Fichoux Y, Quaranta JF, Aufeuvre JP, et al. Occurrence of Leishmania infantum parasitemia in asymptomatic blood donors living in an area of endemicity in southern France. J Clin Microbiol 1999; 37: 1953‐1957.
- 9. Chen X, Zhou Q, Liu J, et al. Autoimmune manifestations of visceral leishmaniasis in Chinese patients. Ann Palliat Med 2021; 10: 12699‐12705.
- 10. Tunccan OG, Tufan A, Telli G, et al. Visceral leishmaniasis mimicking autoimmune hepatitis, primary biliary cirrhosis, and systemic lupus erythematosus overlap. Korean J Parasitol 2012; 50: 133‐136.
- 11. Argov S, Jaffe CL, Krupp M, et al. Autoantibody production by patients infected with Leishmania. Clin Exp Immunol 1989; 76: 190‐197.
- 12. Aronson N, Herwaldt BL, Libman M, et al. Diagnosis and treatment of leishmaniasis: clinical practice guidelines by the Infectious Diseases Society of America (IDSA) and the American Society of Tropical Medicine and Hygiene (ASTMH). Clin Infect Dis 2016; 63: 1539‐1557.



Open access:
Open access publishing facilitated by Monash University, as part of the Wiley ‐ Monash University agreement via the Council of Australian University Librarians.
We thank infectious disease physicians Dr Ouli Xie and Dr Sabine De Silva for their diagnosis and management of visceral leishmaniasis, pathologist Dr Sukhpal Dayan for reporting the patient’s histopathology slides and reviewing the written case report, and microbiology scientist Pei Vern Fong for acquiring the microbiology slides.
No relevant disclosures.